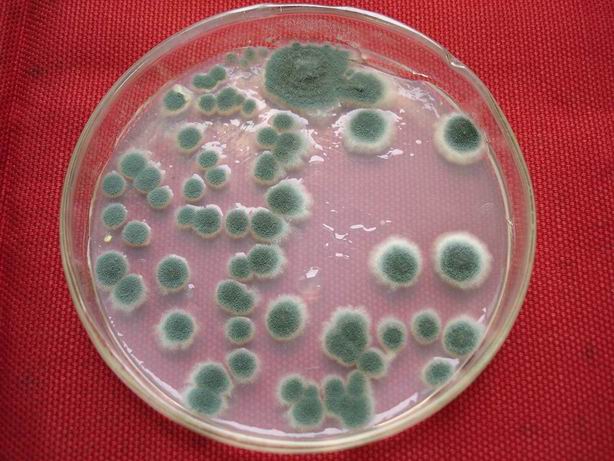
霉菌孢子

霉菌孢子图

显微镜观察霉菌孢子,大家猜一下这是哪种霉菌的孢子.#显微镜 - 抖音
图片尺寸1440x2560
霉菌孢子
图片尺寸450x302
食品生产车间空气中的霉菌孢子可能会对食品安全和产品质量产生潜在
图片尺寸1920x1280
霉菌孢子显微镜94图 霉菌性阴道炎是我国妇科门诊最常见的阴道炎症
图片尺寸1213x1280
检验科镜检~真菌孢子1
图片尺寸1920x1920
霉菌孢子
图片尺寸614x461
霉菌孢子显微镜94图 霉菌性阴道炎是我国妇科门诊最常见的阴道炎症
图片尺寸960x1280
霉菌孢子.jpg
图片尺寸768x576
霉菌孢子显微镜94图 霉菌性阴道炎是我国妇科门诊最常见的阴道炎症
图片尺寸960x1280
霉菌孢子
图片尺寸640x480
霉菌孢子显微镜图
图片尺寸1080x1439
观查砂糖橘发霉后的霉菌形态及孢子
图片尺寸640x480
光学显微镜下的霉菌孢子
图片尺寸2976x3968
链格孢霉孢子
图片尺寸1920x1453
霉菌孢子
图片尺寸3072x2304
霉菌的微距摄影:孢子囊和孢子囊梗清晰可见
图片尺寸1200x675
霉菌孢子
图片尺寸3072x2304
三个霉菌孢子- 3d插图
图片尺寸1200x675
大便常规镜检下的真菌孢子.#显微镜下的世界 #医学科普 #医 - 抖音
图片尺寸918x1224
拍的霉菌孢子照片,请大家帮忙看看是什么霉菌.可能不是很清楚,请
图片尺寸3072x2304